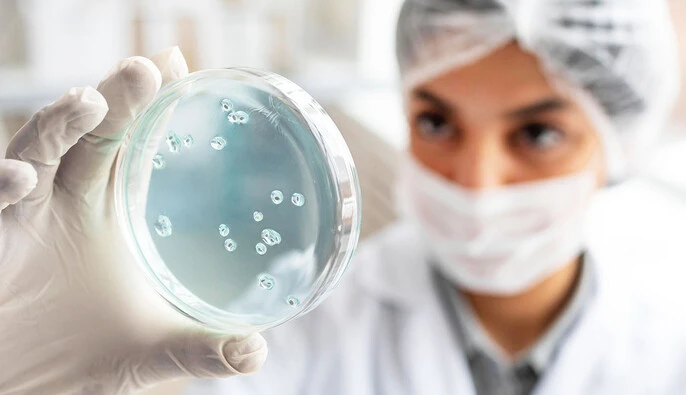
С начала года в Киеве зарегистрировано 13 664 случая гриппа и ОРВИ

С начала года в Киеве зарегистрировано 13 664 случая гриппа и ОРВИ, включая COVID-19 (8 неделя - 13 317).
Об этом сообщает Киевский городской центр контроля и профилактики болезнью.
Недельный показатель заболеваемости - 462,8, что на 15,7% ниже среднего уровня интенсивности (549,09).
Заболели 7380 детей (рост на 7,4%). Доля детей в общей структуре - 54,0%. Среди школьников отмечается снижение заболеваемости на 10,7% - 3984 случая.
"Госпитализированы 306 человек, из них 225 детей (снижение по сравнению с предыдущей неделей). Зарегистрировано 3 летальных исхода (2 — от осложнений COVID-19, 1 — от гриппа). Умершие — лица 65+ с сопутствующими заболеваниями", - сообщили в Центре.
Напомним, в конце ноября в Киеве фиксировали спад заболеваемости ОРВИ и COVID.